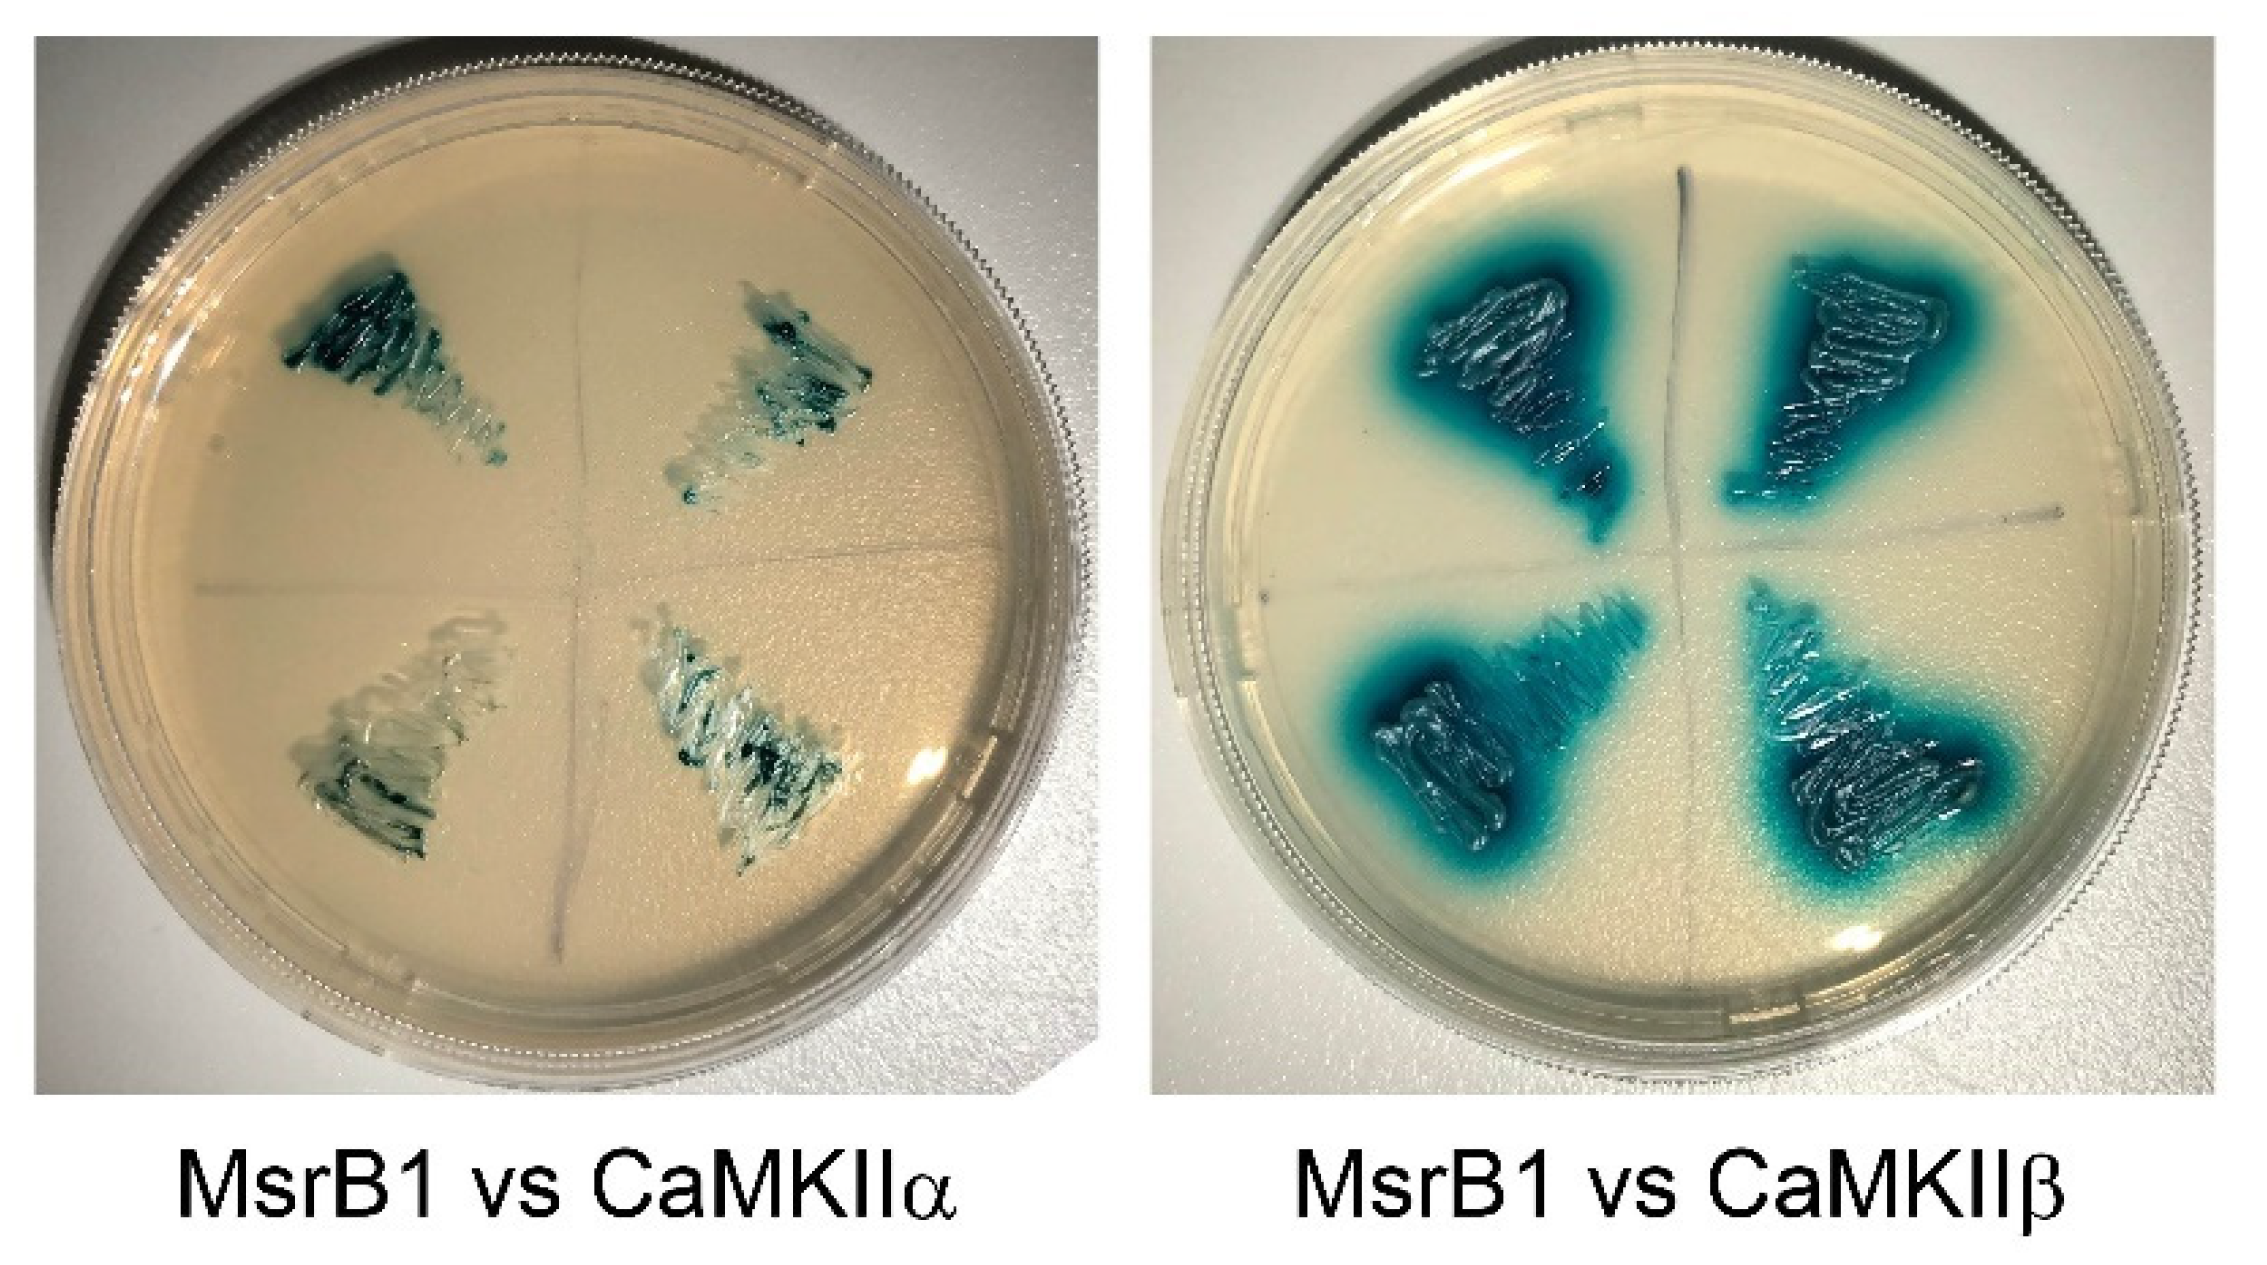
Molecules 26 01372 g002

The Function of Selenium in Central Nervous System: Lessons from MsrB1 Knockout Mouse Models
Abstract
1. Introduction
2. Loss of Msr Resulted in Different Phenotype in Mice
| Msrs | Substrate | Subcellular Localization | Phenotype of KO Mice |
|---|---|---|---|
| MsrA | L-Met-O (S) in or free of proteins [35] | Cytoplasm, nucleus, mitochondria [36,37] | Learning disability, motor behavior disorders, progressive hearing loss [28] |
| MsrB1 | L-Met-O (R) in proteins | Cytoplasm, nucleus [30] | Oxidative stress increase in kidney and liver [30], learning and memory disability [23] |
| MsrB2 | L-Met-O (R) in proteins | Mitochondria [38] | Increased platelet apoptosis [33] |
| MsrB3 | L-Met-O (R) in proteins | Endoplasmic reticulum [22] | Hearing loss [34] |
3. Deficiency of Selenium or Selenoproteins Results in Disfunction of the Brain
4. The Mystery Underlying the Impairment of Synaptic Plasticity in Selenium-Deficient Mice
5. Perspectives
Author Contributions
Funding
Institutional Review Board Statement
Informed Consent Statement
Data Availability Statement
Acknowledgments
Conflicts of Interest
Sample Availability
References
- Toennies, G.A. Sulfoxide of Methionine. Science 1938, 88, 545–546. [Google Scholar] [CrossRef]
- Bennett, M.A. Metabolism of sulphur: The replaceability of dl-methionine in the diet of albino rats with its partially oxidized derivative, dl-methionine sulphoxide. Biochem. J. 1939, 33, 1794–1797. [Google Scholar] [CrossRef]
- Lemoine, F.; Waller, J.P.; Van Rapenbusch, R. Studies on methionyl transfer RNA synthetase. 1. Purification and some properties of methionyl transfer RNA synthetase from Escherichia coli K-12. Eur. J. Biochem. 1968, 4, 213–221. [Google Scholar] [CrossRef]
- Truscott, R.J.; Augusteyn, R.C. Oxidative changes in human lens proteins during senile nuclear cataract formation. Biochim. Biophys. Acta 1977, 492, 43–52. [Google Scholar] [CrossRef]
- Swaim, M.W.; Pizzo, S.V. Methionine sulfoxide and the oxidative regulation of plasma proteinase inhibitors. J. Leukoc. Biol. 1988, 43, 365–379. [Google Scholar] [CrossRef]
- Johnson, D.; Travis, J. Structural evidence for methionine at the reactive site of human alpha-1-proteinase inhibitor. J. Biol. Chem. 1978, 253, 7142–7144. [Google Scholar] [CrossRef]
- Gonzalez Porque, P.; Baldesten, A.; Reichard, P. The involvement of the thioredoxin system in the reduction of methionine sulfoxide and sulfate. J. Biol. Chem. 1970, 245, 2371–2374. [Google Scholar] [CrossRef]
- Ejiri, S.I.; Weissbach, H.; Brot, N. The purification of methionine sulfoxide reductase from Escherichia coli. Anal. Biochem. 1980, 102, 393–398. [Google Scholar] [CrossRef]
- Brot, N.; Weissbach, L.; Werth, J.; Weissbach, H. Enzymatic reduction of protein-bound methionine sulfoxide. Proc. Natl. Acad. Sci. USA 1981, 78, 2155–2158. [Google Scholar] [CrossRef] [PubMed]
- Brot, N.; Werth, J.; Koster, D.; Weissbach, H. Reduction of N-acetyl methionine sulfoxide: A simple assay for peptide methionine sulfoxide reductase. Anal. Biochem. 1982, 122, 291–294. [Google Scholar] [CrossRef]
- Moskovitz, J.; Weissbach, H.; Brot, N. Cloning the expression of a mammalian gene involved in the reduction of methionine sulfoxide residues in proteins. Proc. Natl. Acad. Sci. USA 1996, 93, 2095–2099. [Google Scholar] [CrossRef]
- Achilli, C.; Ciana, A.; Minetti, G. The discovery of methionine sulfoxide reductase enzymes: An historical account and future perspectives. Biofactors 2015, 41, 135–152. [Google Scholar] [CrossRef] [PubMed]
- Rahman, M.A.; Moskovitz, J.; Strassman, J.; Weissbach, H.; Brot, N. Physical map location of the peptide methionine sulfoxide reductase gene on the Escherichia coli chromosome. J. Bacteriol. 1994, 176, 1548–1549. [Google Scholar] [CrossRef] [PubMed][Green Version]
- Kuschel, L.; Hansel, A.; Schönherr, R.; Weissbach, H.; Brot, N.; Hoshi, T.; Heinemann, S.H. Molecular cloning and functional expression of a human peptide methionine sulfoxide reductase (hMsrA). FEBS Lett. 1999, 456, 17–21. [Google Scholar] [CrossRef]
- Grimaud, R.; Ezraty, B.; Mitchell, J.K.; Lafitte, D.; Briand, C.; Derrick, P.J.; Barras, F. Repair of oxidized proteins. Identification of a new methionine sulfoxide reductase. J. Biol. Chem. 2001, 276, 48915–48920. [Google Scholar] [CrossRef] [PubMed]
- Wizemann, T.M.; Moskovitz, J.; Pearce, B.J.; Cundell, D.; Arvidson, C.G.; So, M.; Weissbach, H.; Brot, N.; Masure, H.R. Peptide methionine sulfoxide reductase contributes to the maintenance of adhesins in three major pathogens. Proc. Natl. Acad. Sci. USA 1996, 93, 7985–7990. [Google Scholar] [CrossRef]
- Kryukov, G.V.; Kryukov, V.M.; Gladyshev, V.N. New mammalian selenocysteine-containing proteins identified with an algorithm that searches for selenocysteine insertion sequence elements. J. Biol. Chem. 1999, 274, 33888–33897. [Google Scholar] [CrossRef] [PubMed]
- Lescure, A.; Gautheret, D.; Carbon, P.; Krol, A. Novel selenoproteins identified in silico and in vivo by using a conserved RNA structural motif. J. Biol. Chem. 1999, 274, 38147–38154. [Google Scholar] [CrossRef]
- Huang, W.; Escribano, J.; Sarfarazi, M.; Coca-Prados, M. Identification, expression and chromosome localization of a human gene encoding a novel protein with similarity to the pilB family of transcriptional factors (pilin) and to bacterial peptide methionine sulfoxide reductases. Gene 1999, 233, 233–240. [Google Scholar] [CrossRef]
- Sharov, V.S.; Ferrington, D.A.; Squier, T.C.; Schoneich, C. Diastereoselective reduction of protein-bound methionine sulfoxide by methionine sulfoxide reductase. FEBS Lett. 1999, 455, 247–250. [Google Scholar] [CrossRef]
- Lowther, W.T.; Weissbach, H.; Etienne, F.; Brot, N.; Matthews, B.W. The mirrored methionine sulfoxide reductases of Neisseria gonorrhoeae pilB. Nat. Struct. Biol. 2002, 9, 348–352. [Google Scholar] [CrossRef] [PubMed]
- Kim, H.Y.; Gladyshev, V.N. Characterization of mouse endoplasmic reticulum methionine-R-sulfoxide reductase. Biochem. Biophys. Res. Commun. 2004, 320, 1277–1283. [Google Scholar] [CrossRef]
- Shi, T.; Yang, Y.; Zhang, Z.; Zhang, L.; Song, J.; Ping, Y.; Du, X.; Song, G.; Liu, Q.; Li, N. Loss of MsrB1 perturbs spatial learning and long-term potentiation/long-term depression in mice. Neurobiol. Learn Mem. 2019, 166, 107104. [Google Scholar] [CrossRef] [PubMed]
- Oien, D.B.; Osterhaus, G.L.; Latif, S.A.; Pinkston, J.W.; Fulks, J.; Johnson, M.; Fowler, S.C.; Moskovitz, J. MsrA knockout mouse exhibits abnormal behavior and brain dopamine levels. Free Radic. Biol. Med. 2008, 45, 193–200. [Google Scholar] [CrossRef] [PubMed]
- Brennan, L.A.; Lee, W.; Cowell, T.; Giblin, F.; Kantorow, M. Deletion of mouse MsrA results in HBO-induced cataract: MsrA repairs mitochondrial cytochrome c. Mol. Vis. 2009, 15, 985–999. [Google Scholar] [PubMed]
- Moskovitz, J.; Bar-Noy, S.; Williams, W.M.; Requena, J.; Berlett, B.S.; Stadtman, E.R. Methionine sulfoxide reductase (MsrA) is a regulator of antioxidant defense and lifespan in mammals. Proc. Natl. Acad. Sci. USA 2001, 98, 12920–12925. [Google Scholar] [CrossRef]
- Salmon, A.B.; Pérez, V.I.; Bokov, A.; Jernigan, A.; Kim, G.; Zhao, H.; Levine, R.L.; Richardson, A. Lack of methionine sulfoxide reductase A in mice increases sensitivity to oxidative stress but does not diminish life span. Faseb J. 2009, 23, 3601–3608. [Google Scholar] [CrossRef]
- Alqudah, S.; Chertoff, M.; Durham, D.; Moskovitz, J.; Staecker, H.; Peppi, M. Methionine Sulfoxide Reductase A Knockout Mice Show Progressive Hearing Loss and Sensitivity to Acoustic Trauma. Audiol. Neurootol. 2018, 23, 20–31. [Google Scholar] [CrossRef]
- Lee, B.C.; Péterfi, Z.; Hoffmann, F.W.; Moore, R.E.; Kaya, A.; Avanesov, A.; Tarrago, L.; Zhou, Y.; Weerapana, E.; Fomenko, D.E.; et al. MsrB1 and MICALs regulate actin assembly and macrophage function via reversible stereoselective methionine oxidation. Mol. Cell. 2013, 51, 397–404. [Google Scholar] [CrossRef]
- Fomenko, D.E.; Novoselov, S.V.; Natarajan, S.K.; Lee, B.C.; Koc, A.; Carlson, B.A.; Lee, T.H.; Kim, H.Y.; Hatfield, D.L.; Gladyshev, V.N. MsrB1 (methionine-R-sulfoxide reductase 1) knock-out mice: Roles of MsrB1 in redox regulation and identification of a novel selenoprotein form. J. Biol. Chem. 2009, 284, 5986–5993. [Google Scholar] [CrossRef]
- Kim, K.Y.; Kwak, G.H.; Singh, M.P.; Gladyshev, V.N.; Kim, H.Y. Selenoprotein MsrB1 deficiency exacerbates acetaminophen-induced hepatotoxicity via increased oxidative damage. Arch. Biochem. Biophys. 2017, 634, 69–75. [Google Scholar] [CrossRef]
- Lee, B.C.; Lee, S.G.; Choo, M.K.; Kim, J.H.; Lee, H.M.; Kim, S.; Fomenko, D.E.; Kim, H.Y.; Park, J.M.; Gladyshev, V.N. Selenoprotein MsrB1 promotes anti-inflammatory cytokine gene expression in macrophages and controls immune response in vivo. Sci. Rep. 2017, 7, 5119. [Google Scholar] [CrossRef] [PubMed]
- Lee, S.H.; Lee, S.; Du, J.; Jain, K.; Ding, M.; Kadado, A.J.; Atteya, G.; Jaji, Z.; Tyagi, T.; Kim, W.H.; et al. Mitochondrial MsrB2 serves as a switch and transducer for mitophagy. EMBO. Mol. Med. 2019, 11, e10409. [Google Scholar] [CrossRef]
- Kwon, T.J.; Cho, H.J.; Kim, U.K.; Lee, E.; Oh, S.K.; Bok, J.; Bae, Y.C.; Yi, J.K.; Lee, J.W.; Ryoo, Z.Y.; et al. Methionine sulfoxide reductase B3 deficiency causes hearing loss due to stereocilia degeneration and apoptotic cell death in cochlear hair cells. Hum. Mol. Genet. 2014, 23, 1591–1601. [Google Scholar] [CrossRef]
- Moskovitz, J.; Poston, J.M.; Berlett, B.S.; Nosworthy, N.J.; Szczepanowski, R.; Stadtman, E.R. Identification and characterization of a putative active site for peptide methionine sulfoxide reductase (MsrA) and its substrate stereospecificity. J. Biol. Chem. 2000, 275, 14167–14172. [Google Scholar] [CrossRef] [PubMed]
- Kim, H.Y.; Gladyshev, V.N. Role of structural and functional elements of mouse methionine-S-sulfoxide reductase in its subcellular distribution. Biochemistry 2005, 44, 8059–8067. [Google Scholar] [CrossRef]
- Haenold, R.; Wassef, R.; Hansel, A.; Heinemann, S.H.; Hoshi, T. Identification of a new functional splice variant of the enzyme methionine sulphoxide reductase A (MSRA) expressed in rat vascular smooth muscle cells. Free Radic. Res. 2007, 41, 1233–1245. [Google Scholar] [CrossRef] [PubMed]
- Cabreiro, F.; Picot, C.R.; Perichon, M.; Castel, J.; Friguet, B.; Petropoulos, I. Overexpression of mitochondrial methionine sulfoxide reductase B2 protects leukemia cells from oxidative stress-induced cell death and protein damage. J. Biol. Chem. 2008, 283, 16673–16681. [Google Scholar] [CrossRef] [PubMed]
- Reich, H.J.; Hondal, R.J. Why Nature Chose Selenium. ACS Chem. Biol. 2016, 11, 821–841. [Google Scholar] [CrossRef] [PubMed]
- Vinceti, M.; Wei, E.T.; Malagoli, C.; Bergomi, M.; Vivoli, G. Adverse health effects of selenium in humans. Rev. Environ. Health 2001, 16, 233–251. [Google Scholar] [CrossRef] [PubMed]
- Aterman, K. Selenium and liver necrosis in the hyperthyroid rat. Nature 1958, 182, 1514. [Google Scholar] [CrossRef]
- Pinsent, J. The need for selenite and molybdate in the formation of formic dehydrogenase by members of the coli-aerogenes group of bacteria. Biochem. J. 1954, 57, 10–16. [Google Scholar] [CrossRef] [PubMed]
- Neve, J.; Vertongen, F.; Molle, L. Selenium deficiency. Clin. Endocrinol. Metab. 1985, 14, 629–656. [Google Scholar] [CrossRef]
- Labunskyy, V.M.; Hatfield, D.L.; Gladyshev, V.N. Selenoproteins: Molecular pathways and physiological roles. Physiol. Rev. 2014, 94, 739–777. [Google Scholar] [CrossRef] [PubMed]
- Gladyshev, V.N.; Arner, E.S.; Berry, M.J.; Brigelius-Flohe, R.; Bruford, E.A.; Burk, R.F.; Carlson, B.A.; Castellano, S.; Chavatte, L.; Conrad, M.; et al. Selenoprotein Gene Nomenclature. J. Biol. Chem. 2016, 291, 24036–24040. [Google Scholar] [CrossRef] [PubMed]
- Soerensen, J.; Jakupoglu, C.; Beck, H.; Forster, H.; Schmidt, J.; Schmahl, W.; Schweizer, U.; Conrad, M.; Brielmeier, M. The role of thioredoxin reductases in brain development. PLoS ONE 2008, 3, e1813. [Google Scholar] [CrossRef]
- Jakupoglu, C.; Przemeck, G.K.H.; Schneider, M.; Moreno, S.G.; Mayr, N.; Hatzopoulos, A.K.; De Angelis, M.H.; Wurst, W.; Bornkamm, G.W.; Brielmeier, M.; et al. Cytoplasmic thioredoxin reductase is essential for embryogenesis but dispensable for cardiac development. Mol. Cell. Biol. 2005, 25, 1980–1988. [Google Scholar] [CrossRef]
- Conrad, M.; Jakupoglu, C.; Moreno, S.G.; Lippl, S.; Banjac, A.; Schneider, M.; Beck, H.; Hatzopoulos, A.K.; Just, U.; Sinowatz, F.; et al. Essential role for mitochondrial thioredoxin reductase in hematopoiesis, heart development, and heart function. Mol. Cell. Biol. 2004, 24, 9414–9423. [Google Scholar] [CrossRef]
- Hill, K.E.; Lloyd, R.S.; Yang, J.G.; Read, R.; Burk, R.F. The cDNA for rat selenoprotein P contains 10 TGA codons in the open reading frame. J. Biol. Chem. 1991, 266, 10050–10053. [Google Scholar] [CrossRef]
- Hill, K.E.; Zhou, J.; Mcmahan, W.J.; Motley, A.K.; Atkins, J.F.; Gesteland, R.F.; Burk, R.F. Deletion of selenoprotein P alters distribution of selenium in the mouse. J. Biol. Chem. 2003, 278, 13640–13646. [Google Scholar] [CrossRef]
- Valentine, W.M.; Hill, K.E.; Austin, L.M.; Valentine, H.L.; Goldowitz, D.; Burk, R.F. Brainstem axonal degeneration in mice with deletion of selenoprotein p. Toxicol. Pathol. 2005, 33, 570–576. [Google Scholar] [CrossRef]
- Peters, M.M.; Hill, K.E.; Burk, R.F.; Weeber, E.J. Altered hippocampus synaptic function in selenoprotein P deficient mice. Mol. Neurodegener. 2006, 1, 12. [Google Scholar] [CrossRef] [PubMed]
- Burk, R.F.; Hill, K.E.; Olson, G.E.; Weeber, E.J.; Motley, A.K.; Winfrey, V.P.; Austin, L.M. Deletion of apolipoprotein E receptor-2 in mice lowers brain selenium and causes severe neurological dysfunction and death when a low-selenium diet is fed. J. Neurosci. 2007, 27, 6207–6211. [Google Scholar] [CrossRef]
- Raman, A.V.; Pitts, M.W.; Seyedali, A.; Hashimoto, A.C.; Seale, L.A.; Bellinger, F.P.; Berry, M.J. Absence of selenoprotein P but not selenocysteine lyase results in severe neurological dysfunction. Genes. Brain. Behav. 2012, 11, 601–613. [Google Scholar] [CrossRef] [PubMed]
- Castex, M.T.; Arabo, A.; Benard, M.; Roy, V.; Le Joncour, V.; Prevost, G.; Bonnet, J.J.; Anouar, Y.; Falluel-Morel, A. Selenoprotein T Deficiency Leads to Neurodevelopmental Abnormalities and Hyperactive Behavior in Mice. Mol. Neurobiol. 2016, 53, 5818–5832. [Google Scholar] [CrossRef] [PubMed]
- Agamy, O.; Ben Zeev, B.; Lev, D.; Marcus, B.; Fine, D.; Su, D.; Narkis, G.; Ofir, R.; Hoffmann, C.; Leshinsky-Silver, E.; et al. Mutations disrupting selenocysteine formation cause progressive cerebello-cerebral atrophy. Am. J. Hum. Genet. 2010, 87, 538–544. [Google Scholar] [CrossRef] [PubMed]
- Schomburg, L.; Schweizer, U.; Holtmann, B.; Flohé, L.; Sendtner, M.; Köhrle, J. Gene disruption discloses role of selenoprotein P in selenium delivery to target tissues. Biochem. J. 2003, 370, 397–402. [Google Scholar] [CrossRef]
- Chen, P.; Wang, C.; Ma, X.; Zhang, Y.; Liu, Q.; Qiu, S.; Liu, Q.; Tian, J.; Ni, J. Direct Interaction of Selenoprotein R with Clusterin and Its Possible Role in Alzheimer’s Disease. PLoS ONE 2013, 8, e66384. [Google Scholar] [CrossRef] [PubMed]
- Harold, D.; Abraham, R.; Hollingworth, P.; Sims, R.; Gerrish, A.; Hamshere, M.L.; Pahwa, J.S.; Moskvina, V.; Dowzell, K.; Williams, A.; et al. Genome-wide association study identifies variants at CLU and PICALM associated with Alzheimer’s disease. Nat. Genet. 2009, 41, 1088–1093. [Google Scholar] [CrossRef]
- Cao, G.; Lee, K.P.; Van Der Wijst, J.; De Graaf, M.; Van Der Kemp, A.; Bindels, R.J.; Hoenderop, J.G. Methionine sulfoxide reductase B1 (MsrB1) recovers TRPM6 channel activity during oxidative stress. J. Biol. Chem. 2010, 285, 26081–26087. [Google Scholar] [CrossRef]
- Bayer, K.U.; Schulman, H. CaM Kinase: Still Inspiring at 40. Neuron 2019, 103, 380–394. [Google Scholar] [CrossRef] [PubMed]
- Huganir, R.L.; Nicoll, R.A. AMPARs and Synaptic Plasticity: The Last 25 Years. Neuron 2013, 80, 704–717. [Google Scholar] [CrossRef]
- Erickson, J.R.; Joiner, M.L.; Guan, X.; Kutschke, W.; Yang, J.; Oddis, C.V.; Bartlett, R.K.; Lowe, J.S.; O’donnell, S.E.; Aykin-Burns, N.; et al. A dynamic pathway for calcium-independent activation of CaMKII by methionine oxidation. Cell 2008, 133, 462–474. [Google Scholar] [CrossRef] [PubMed]
- Coultrap, S.J.; Bayer, K.U. Nitric Oxide Induces Ca2+-independent Activity of the Ca2+/Calmodulin-dependent Protein Kinase II (CaMKII). J. Bio. Chem. 2014, 289, 19458–19465. [Google Scholar] [CrossRef]
- Hung, R.J.; Yazdani, U.; Yoon, J.; Wu, H.; Yang, T.; Gupta, N.; Huang, Z.; Van Berkel, W.J.; Terman, J.R. Mical links semaphorins to F-actin disassembly. Nature 2010, 463, 823–827. [Google Scholar] [CrossRef]
- Moskovitz, J.; Du, F.; Bowman, C.F.; Yan, S.S. Methionine sulfoxide reductase A affects beta-amyloid solubility and mitochondrial function in a mouse model of Alzheimer’s disease. Am. J. Physiol. Endocrinol. Metab. 2016, 310, E388–E393. [Google Scholar] [CrossRef]
- Adams, S.L.; Benayoun, L.; Tilton, K.; Chavez, O.R.; Himali, J.J.; Blusztajn, J.K.; Seshadri, S.; Delalle, I. Methionine Sulfoxide Reductase-B3 (MsrB3) Protein Associates with Synaptic Vesicles and its Expression Changes in the Hippocampi of Alzheimer’s Disease Patients. J. Alzheimers Dis. 2017, 60, 43–56. [Google Scholar] [CrossRef] [PubMed]
- Mohamed, T.; Shakeri, A.; Rao, P.P. Amyloid cascade in Alzheimer’s disease: Recent advances in medicinal chemistry. Eur. J. Med. Chem. 2016, 113, 258–272. [Google Scholar] [CrossRef]
- Karch, C.M.; Goate, A.M. Alzheimer’s disease risk genes and mechanisms of disease pathogenesis. Biol. Psychiatry 2015, 77, 43–51. [Google Scholar] [CrossRef] [PubMed]
- Wang, C.; Chen, P.; He, X.; Peng, Z.; Chen, S.; Zhang, R.; Cheng, J.; Liu, Q. Direct interaction between selenoprotein R and Abeta42. Biochem. Biophys. Res. Commun. 2017, 489, 509–514. [Google Scholar] [CrossRef] [PubMed]
- Cummings, J.L.; Morstorf, T.; Zhong, K. Alzheimer’s disease drug-development pipeline: Few candidates, frequent failures. Alzheimers Res. Ther. 2014, 6, 37. [Google Scholar] [CrossRef] [PubMed]
- Cummings, J.; Lee, G.; Mortsdorf, T.; Ritter, A.; Zhong, K. Alzheimer’s disease drug development pipeline: 2017. Alzheimers Dement (NY) 2017, 3, 367–384. [Google Scholar] [CrossRef] [PubMed]
- Bezprozvanny, I.; Mattson, M.P. Neuronal calcium mishandling and the pathogenesis of Alzheimer’s disease. Trends Neurosci. 2008, 31, 454–463. [Google Scholar] [CrossRef]
- Popugaeva, E.; Pchitskaya, E.; Bezprozvanny, I. Dysregulation of neuronal calcium homeostasis in Alzheimer’s disease - A therapeutic opportunity? Biochem. Biophys. Res. Commun. 2017, 483, 998–1004. [Google Scholar] [CrossRef] [PubMed]
- Kumar, A.; Bodhinathan, K.; Foster, T.C. Susceptibility to Calcium Dysregulation during Brain Aging. Front. Aging Neurosci. 2009, 1, 2. [Google Scholar] [CrossRef] [PubMed]
- Bezprozvanny, I. Calcium signaling and neurodegenerative diseases. Trends Mol. Med. 2009, 15, 89–100. [Google Scholar] [CrossRef]
- Ferreira, I.L.; Bajouco, L.M.; Mota, S.I.; Auberson, Y.P.; Oliveira, C.R.; Rego, A.C. Amyloid beta peptide 1-42 disturbs intracellular calcium homeostasis through activation of GluN2B-containing N-methyl-d-aspartate receptors in cortical cultures. Cell Calcium 2012, 51, 95–106. [Google Scholar] [CrossRef]
- Lipton, S.A. Pathologically activated therapeutics for neuroprotection. Nat. Rev. Neurosci. 2007, 8, 803–808. [Google Scholar] [CrossRef] [PubMed]
- Song, G.; Zhang, Z.; Wen, L.; Chen, C.; Shi, Q.; Zhang, Y.; Ni, J.; Liu, Q. Selenomethionine ameliorates cognitive decline, reduces tau hyperphosphorylation, and reverses synaptic deficit in the triple transgenic mouse model of Alzheimer’s disease. J. Alzheimers Dis. 2014, 41, 85–99. [Google Scholar] [CrossRef]
- Zhang, Z.H.; Chen, C.; Wu, Q.Y.; Zheng, R.; Liu, Q.; Ni, J.Z.; Hoffmann, P.R.; Song, G.L. Selenomethionine reduces the deposition of beta-amyloid plaques by modulating beta-secretase and enhancing selenoenzymatic activity in a mouse model of Alzheimer’s disease. Metallomics 2016, 8, 782–789. [Google Scholar] [CrossRef]
- Zhang, Z.H.; Wu, Q.Y.; Zheng, R.; Chen, C.; Chen, Y.; Liu, Q.; Hoffmann, P.R.; Ni, J.Z.; Song, G.L. Selenomethionine Mitigates Cognitive Decline by Targeting Both Tau Hyperphosphorylation and Autophagic Clearance in an Alzheimer’s Disease Mouse Model. J. Neurosci. 2017, 37, 2449–2462. [Google Scholar] [CrossRef]
- Goedert, M.; Cohen, E.S.; Jakes, R.; Cohen, P. p42 MAP kinase phosphorylation sites in microtubule-associated protein tau are dephosphorylated by protein phosphatase 2A1. Implications for Alzheimer’s disease. FEBS Lett. 1992, 312, 95–99. [Google Scholar] [CrossRef]
- Longin, S.; Zwaenepoel, K.; Louis, J.V.; Dilworth, S.; Goris, J.; Janssens, V. Selection of protein phosphatase 2A regulatory Subunits is mediated by the C terminus of the catalytic subunit. J. Biol. Chem. 2007, 282, 26971–26980. [Google Scholar] [CrossRef] [PubMed]
- Habbab, W.; Aoude, I.; Palangi, F.; Abdulla, S.; Ahmed, T. The Anti-Tumor Agent Sodium Selenate Decreases Methylated PP2A, Increases GSK3Y216 Phosphorylation, Including Tau Disease Epitopes and Reduces Neuronal Excitability in SHSY-5Y Neurons. Inter. J. Mol. Sci. 2019, 20, 844. [Google Scholar] [CrossRef] [PubMed]
- Yeo, J.E.; Kang, S.K. Selenium effectively inhibits ROS-mediated apoptotic neural precursor cell death in vitro and in vivo in traumatic brain injury. Biochim. Biophys. Acta 2007, 1772, 1199–1210. [Google Scholar] [CrossRef] [PubMed]
- Tian, D.P.; Su, M.; Wu, X.Y.; Zhang, G. Effects of selenium and B-27 supplements on viability and differentiation of neural stem cell in newborn rat. Zhonghua Yu Fang Yi Xue Za Zhi 2005, 39, 324–327. [Google Scholar]
- Kryscio, R.J.; Abner, E.L.; Caban-Holt, A.; Lovell, M.; Goodman, P.; Darke, A.K.; Yee, M.; Crowley, J.; Schmitt, F.A. Association of Antioxidant Supplement Use and Dementia in the Prevention of Alzheimer’s Disease by Vitamin E and Selenium Trial (PREADViSE). JAMA Neurol. 2017, 74, 567–573. [Google Scholar] [CrossRef]

Publisher’s Note: MDPI stays neutral with regard to jurisdictional claims in published maps and institutional affiliations. |
© 2021 by the authors. Licensee MDPI, Basel, Switzerland. This article is an open access article distributed under the terms and conditions of the Creative Commons Attribution (CC BY) license (http://creativecommons.org/licenses/by/4.0/).
Share and Cite
Shi, T.; Song, J.; You, G.; Yang, Y.; Liu, Q.; Li, N. The Function of Selenium in Central Nervous System: Lessons from MsrB1 Knockout Mouse Models. Molecules 2021, 26, 1372. https://doi.org/10.3390/molecules26051372
Shi T, Song J, You G, Yang Y, Liu Q, Li N. The Function of Selenium in Central Nervous System: Lessons from MsrB1 Knockout Mouse Models. Molecules. 2021; 26(5):1372. https://doi.org/10.3390/molecules26051372
Chicago/Turabian StyleShi, Tengrui, Jianxi Song, Guanying You, Yujie Yang, Qiong Liu, and Nan Li. 2021. "The Function of Selenium in Central Nervous System: Lessons from MsrB1 Knockout Mouse Models" Molecules 26, no. 5: 1372. https://doi.org/10.3390/molecules26051372
APA StyleShi, T., Song, J., You, G., Yang, Y., Liu, Q., & Li, N. (2021). The Function of Selenium in Central Nervous System: Lessons from MsrB1 Knockout Mouse Models. Molecules, 26(5), 1372. https://doi.org/10.3390/molecules26051372

